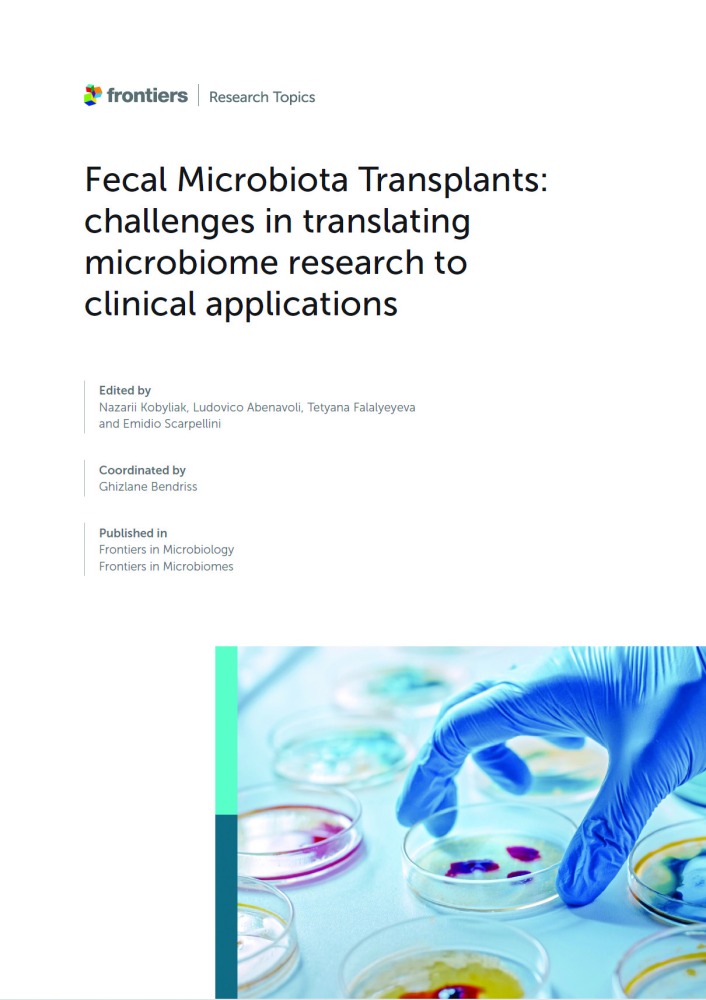

أعلنت وزارة البلدية عن إغلاق هايبر ماركت لمخالفته قانون تنظيم الأغذية الآدمية رقم 8 لسنة 1990 بشأن تنظيم مراقبة الأغذية الآدمية المعدل بالقانون...
رئيس مجلس الإدارة : د. خالد بن ثاني آل ثاني

رئيس التحرير: جابر سالم الحرمي

مساحة إعلانية
مساحة إعلانية
تواصل جامعات قطر تعزيز دمج الذكاء الاصطناعي ببحوث الجينيوم والبروتيوم . وفي هذا الاطار تولّت الدكتورة غزلان بن دريس الأستاذ المساعد لعلم الأحياء والباحثة في وايل كورنيل للطب - قطر جهود نشر كتاب إلكتروني يجمع بين دفتيه أحدث البحوث المتعلقة باستخدام عمليات زرع ميكروبات الفضلات لاستعادة ميكروبات الأمعاء الصحية.
وحصد الكتاب الذي نُشر باللغة الإنجليزية بعنوان «زرع ميكروبات الفضلات : تحديات ترجمة بحوث الميكروبيوم إلى تطبيقات إكلينيكية»، اهتماماً واسعاً في أوساط العلماء والأطباء، ما جعل الدورية العلمية Frontiers in Microbiology الناشرة له تقرّر إصدار نسخة ثانية منه السنة القادمة. وتضمّن المجلد الأول الذي سجّل أكثر من 100 ألف مطالَعة في شهر واحد فقط منذ نشره، 26 مقالة بحثية تناولت التحديات التي تحُول دون اعتماد زرع الميكروبات في الممارسة الإكلينيكية السائدة.
وفي هذا الصدد، أشارت الدكتورة بن دريس إلى أن التطورات التي تشهدها العلوم الجينومية والبروتيومية والعلوم ذات الصلة تُدمَج اليوم على نحو متزايد مع الذكاء الاصطناعي لتمكين العلماء من رصد الأنماط على نطاق واسع والدراسة المتعمقة للعمليات الأيضية وتتيح أدوات جديدة لاختبار فعالية عمليات زرع ميكروبات الفضلات. وتتبوأ وايل كورنيل للطب - قطر مكانة إقليمية ريادية في دراسة العلوم الجينومية والبروتيومية والعلوم ذات الصلة، بما في ذلك العلوم الأيضية والميتاجينومية والبروتينية، كما طوّرت الكلية قدرات متقدمة في بحوث الذكاء الاصطناعي وتعلُّم الآلة في السنوات الأخيرة.
مساحة إعلانية
مساحة إعلانية
أعلنت وزارة البلدية عن إغلاق هايبر ماركت لمخالفته قانون تنظيم الأغذية الآدمية رقم 8 لسنة 1990 بشأن تنظيم مراقبة الأغذية الآدمية المعدل بالقانون...
40738
| 25 يناير 2026
أعلنت اللجنة الدائمة الموحدة لاختيار مرشحي ضباط الجهات العسكرية، عن فتح باب التسجيل للكليات العسكرية والأمنية لحملة الشهادة الثانوية العامة وما يعادلها للعام...
22160
| 24 يناير 2026
حذرالمتنبئ الجوي بالهيئة العامة للطيران المدني،صقر السويدي،من حالة الطقس خلال الفترة المقبلة في ظل الموجة الغبارية التي شهدتها قطر اليوم. وقال خلال مداخلة...
16050
| 25 يناير 2026
أكد رامز الخياط، الرئيس التنفيذي لمجموعة باور إنترناشونال القابضة والرئيس التنفيذي في شركة أورباكون القابضة أن مشروعي شركاته في تطوير وتشغيل مطار دمشق...
7916
| 24 يناير 2026
مساحة إعلانية
مساحة إعلانية
ارتفع الذهب اليوم بعد أن تجاوز مستوى 5100 دولار للمرة الأولى في الجلسة السابقة، مع استمرار الطلب على الملاذ الآمن وسط حالة عدم...
0
| 27 يناير 2026
فيما يلي بيان بأسعار بعض العملات الأجنبية مقابل الريال القطري، كما وردت من بنك قطر الوطني اليوم: العملة الشراء البيع ريال سعودي 0.96400...
34
| 27 يناير 2026
كرَّمت الهيئة العامة للجمارك، غرفة قطر على دعمها الدائم للهيئة، حيث قام سعادة السيد علي بن أحمد الكواري وزير المالية بتسليم شهادة التكريم...
82
| 27 يناير 2026
أطلق البنك الأهلي حملة حساب توفير الرابح 2026، التي تتيح للعملاء فرصة الادخار والدخول في سحوبات على جوائز مميزة على مدار العام. وتعكس...
54
| 27 يناير 2026
مساحة إعلانية
تابع الأخبار المحلية والعالمية من خلال تطبيقات الجوال المتاحة على متجر جوجل ومتجر آبل




حذرت إدارة الأرصاد الجوية من أمطار رعدية متوقعة ورياح قوية ورؤية أفقية متدنية على الساحل، ومن أمطار رعدية متوقعة ورياح قوية وأمواج عالية...
6838
| 25 يناير 2026
كشفت السيدة مها زايد القعقاع الرويلي، الوكيل المساعد لقطاع الشؤون التعليمية بوزارة التربية والتعليم والتعليم العالي، في تصريح خاص لـ «الشرق»، عن الانتهاء...
6808
| 25 يناير 2026
أعلنت إدارة الأرصاد الجوية، التابعة للهيئة العامة للطيران المدني، أن آخر الصور الجوية توضح اقتراب كتلة غبارية من أجواء البلاد، ومن المتوقع أن...
5444
| 25 يناير 2026